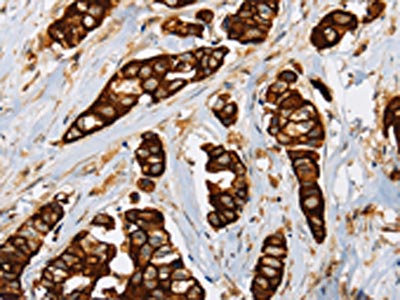

TLR6 Antibody
-
中文名稱:TLR6兔多克隆抗體
-
貨號:CSB-PA086865
-
規格:¥1100
-
圖片:
-
The image on the left is immunohistochemistry of paraffin-embedded Human thyroid cancer tissue using CSB-PA086865(TLR6 Antibody) at dilution 1/25, on the right is treated with fusion protein. (Original magnification: ×200)
-
The image on the left is immunohistochemistry of paraffin-embedded Human breast cancer tissue using CSB-PA086865(TLR6 Antibody) at dilution 1/25, on the right is treated with fusion protein. (Original magnification: ×200)
-
-
其他:
產品詳情
-
Uniprot No.:
-
基因名:
-
別名:CD286 antibody; CD286 antigen antibody; TLR 6 antibody; Tlr6 antibody; TLR6_HUMAN antibody; Toll like receptor 6 precursor antibody; Toll-like receptor 6 antibody
-
宿主:Rabbit
-
反應種屬:Human
-
免疫原:Fusion protein of Human TLR6
-
免疫原種屬:Homo sapiens (Human)
-
標記方式:Non-conjugated
-
抗體亞型:IgG
-
純化方式:Antigen affinity purification
-
濃度:It differs from different batches. Please contact us to confirm it.
-
保存緩沖液:-20°C, pH7.4 PBS, 0.05% NaN3, 40% Glycerol
-
產品提供形式:Liquid
-
應用范圍:ELISA,IHC
-
推薦稀釋比:
Application Recommended Dilution ELISA 1:2000-1:5000 IHC 1:50-1:200 -
Protocols:
-
儲存條件:Upon receipt, store at -20°C or -80°C. Avoid repeated freeze.
-
貨期:Basically, we can dispatch the products out in 1-3 working days after receiving your orders. Delivery time maybe differs from different purchasing way or location, please kindly consult your local distributors for specific delivery time.
-
用途:For Research Use Only. Not for use in diagnostic or therapeutic procedures.
相關產品
靶點詳情
-
功能:Participates in the innate immune response to Gram-positive bacteria and fungi. Specifically recognizes diacylated and, to a lesser extent, triacylated lipopeptides. In response to diacylated lipopeptides, forms the activation cluster TLR2:TLR6:CD14:CD36, this cluster triggers signaling from the cell surface and subsequently is targeted to the Golgi in a lipid-raft dependent pathway. Acts via MYD88 and TRAF6, leading to NF-kappa-B activation, cytokine secretion and the inflammatory response. Recognizes mycoplasmal macrophage-activating lipopeptide-2kD (MALP-2), soluble tuberculosis factor (STF), phenol-soluble modulin (PSM) and B.burgdorferi outer surface protein A lipoprotein (OspA-L) cooperatively with TLR2. In complex with TLR4, promotes sterile inflammation in monocytes/macrophages in response to oxidized low-density lipoprotein (oxLDL) or amyloid-beta 42. In this context, the initial signal is provided by oxLDL- or amyloid-beta 42-binding to CD36. This event induces the formation of a heterodimer of TLR4 and TLR6, which is rapidly internalized and triggers inflammatory response, leading to the NF-kappa-B-dependent production of CXCL1, CXCL2 and CCL9 cytokines, via MYD88 signaling pathway, and CCL5 cytokine, via TICAM1 signaling pathway, as well as IL1B secretion.
-
基因功能參考文獻:
- Live Faecalibacterium prausnitzii, an abundant obligate anaerobe of the colonic microbiota, induced higher TLR2 and TLR2/6 activation than the dead bacterium. PMID: 29112296
- mean proportions of European ancestry differed significantly between the genotypes of the TLR1 (I602S) gene in a population of the Atlantic Forest, Sao Paulo, Brazil PMID: 29175392
- Identification of TLR2/TLR6 signalling lactic acid bacteria for supporting immune regulation. PMID: 27708357
- recombinant NS1, expressed and purified from eukaryotic cells, induces cytokine production via TLR4 but not TLR2/6. PMID: 28220810
- TLR6 role in Kawasaki disease susceptibility in African American family PMID: 28151979
- The mRNA levels of Toll-like receptors TLR2, 6, and 9 were significantly elevated in the Kawasaki disease (KD) patient group versus the healthy controls. PMID: 28061462
- Significant correlations with atherosclerosis susceptibility were found for the toll like receptor 1 (TLR1) rs5743551 polymorphism and toll like receptor 6 (TLR6) rs5743810 polymorphism. PMID: 28474755
- Study concludes that genetic variation in the TLR10-TLR1-TLR6 gene cluster mediates responsiveness to organic dust, but indicates different signaling pathways for IL-6 and TNF-alpha. These studies provide new insight into the role of the TLR10-TLR1-TLR6 gene cluster and the innate immune response to organic dust. PMID: 28123183
- Studied the relationship between polymorphisms in MBL, TLR1, TLR2 and TLR6 encoding genes and stimulated IFN-gamma and IL-12 ex vivo production in BCG osteitis survivors. Found that variant genotypes of the MBL2 gene (if homozygous) and variant genotypes of the TLR2 gene (only heterozygotes present) are associated with low IFN-gamma production. PMID: 27755461
- efficient method for preparation of the extracellular domain of human Toll-like receptor 6 (TLR6ED) in Escherichia coli using the bubbling cultivation method. Our preparation method improved the level of expression of TLR6ED into a soluble fraction as compared with typical cultivation using a rotary shaker. Circular dichroism (CD) experiments confirmed the structural formation of TLR6ED with secondary structure contents PMID: 28161794
- Toll-like receptor 6 (TLR6) is significantly overexpressed in the hepatocytes of non-alcoholic fatty liver disease (NAFLD patients compared to their normal counterparts. PMID: 27834919
- study demonstrates a significant association between TLR4 rs192791 and TLR6 rs1039559 SNPs and posttransplantation diabetes mellitus in renal transplantation recipients PMID: 27486667
- genetic polymorphism is associated with malaria disease progression in Indian patients PMID: 26621243
- Study showed that MyD88 Toll/interleukin-1 receptor (TIR) domain interacted with TLR5TIR but not with TLR6TIR. The solubility of both TLR5TIR and TLR6TIR were influenced by its binding partner MyD88TIR. PMID: 26548862
- Study annotated variants at 4p14 as expression quantitative trait loci (eQTL) associated with TLR6/10 and FAM114A1; findings suggest that 4p14 polymorphisms are linked to host immune response to H. pylori infection but not to its acquisition. PMID: 26312625
- OSA patients had increased TLR2/6 co-expressions on blood immune cells, which were related to their immune cell counts and could be reversed with CPAP treatment. In vitro IHR could induce TLR2/6 co-upregulation. PMID: 25604476
- TLR7 rs179008 showed some associations with post-bronchiolitis lung function deficiency, and polymorphisms of TLR4 rs4986790, and TLR6 rs5743810 in particular, with airway reactivity. PMID: 26741133
- Dengue virus NS1 protein is the viral protein responsible for the activation of TLR2 and TLR6 during Dengue virus infection PMID: 26226614
- study found TLR6 gene rs3775073 polymorphism may be associated with 2-fold decrease of infective endocarditis risk PMID: 25213166
- C745T genotype associated with elevated risk of Bacillus Calmette-Guerin osteitis following infant vaccination PMID: 25605403
- Suggest genetic polymorphisms in TLR3/6 may have a plausible role in the occurrence of severe acute pancreatitis. PMID: 25423559
- Frequencies of TLR1-TLR6 two-locus haplotypes in major populations of South Urals were determined for the first time PMID: 26470427
- these data indicated that TLR6 V327M may be involved in mediating deleterious inflammatory responses and modulating host susceptibility to Klebsiella pneumonia. PMID: 24797996
- A novel mechanism for inducing CXCL10 production directly from melanoma cells, with TLR2/6 agonists +IFNgamma. PMID: 25765738
- expression is increased in both maternal part and fetal part of the placenta in Iranian women with preeclampsia PMID: 25549591
- Genetic variation rs5743565 in TLR1 might be associated with the decreased susceptibility to Graves disease, whlie polymorphisms in TLR6 and TLR10 did not reach the statistical significance. PMID: 25028161
- The correlation between TLR1, TLR6, and TLR10 polymorphisms and the development of atopic dermatitis in the Republic of Bashkortostan has been found. PMID: 25850295
- SNPs in the exons of TLR1 and TLR6 are associated with susceptibility to type 1 diabetes in the Chinese population. PMID: 25261617
- Data show that a total of nine single-nucleotide polymorphisms (SNPs) in TLR1, TLR4, TLR6 and TLR8 in Caucasians, and two other SNPs, one each in Toll-like receptors TLR4 and TLR8, in African Americans were significantly associated with HIV status. PMID: 25253287
- TLR6 instructs specific classes of dendrites in the synapses of the olfactory circuit in transgenic Drosophila. PMID: 25741726
- C745T polymorphism not associated with severity of bronchiolitis or risk of postbronchiolitis wheezing PMID: 24112285
- Transmembrane oligomeric form of Vibrio cholerae cytolysin (VCC) triggers TLR2/TLR6-dependent proinflammatory responses in monocytes and macrophages. PMID: 25431887
- No association was observed for either TLR1 1805 T>G or TLR6 745 C>T polymorphism and pulmonary tuberculosis. PMID: 24984237
- TLR6 (a C-->T mutation at position 745) polymorphism is associated with an increased risk of both laboratory- and clinically-defined neurosyphilis. PMID: 24922103
- Under treatment with MMC and hydrostatic pressure, UC cells showed increasing apoptosis using extrinsic pathways through upregulation of TLR6 and CTGF PMID: 24689870
- TLR2 and its co-receptors, TLR1 and TLR6, contribute to the pathogenicity of aPLA; aPLA are internalized via clathrin- and CD14-dependent endocytosis; and endocytosis is required for NF-kappaB activation PMID: 24612386
- this study reports the first crystal structure of the TIR domain of TLR6 at 2.2 A resolution. PMID: 25088687
- Authors demonstrated that TLR1 rs5743618 was associated with asthma and atopic eczema during the first 6 years of life after early bronchiolitis and TLR6 rs5743810 was associated with present atopy at preschool age. PMID: 24445834
- In the genetic association analysis, polymorphisms in TLR1 (S248N and R80T), TLR2 (P631H), and TLR6 (P249S) were associated with an increased susceptibility to complicated skin and skin structure infections. PMID: 24511099
- TLR6 variant, 359T>C, is an independent risk factor for Legionnaire disease. PMID: 23823019
- Studied association between single nucleotide polymorphism in toll-like receptor 6 and a decreased risk for ureaplasma respiratory tract colonization and bronchopulmonary dysplasia in preterm infants. PMID: 23518821
- The 663leucine and 688aspragine residues outside of the BB loop are essential for the responsiveness of TLR2/2, TLR2/1 and TLR2/6, but the 681proline residue inside of the BB loop exhibits divergent roles in TLR2/2, TLR2/1 and TLR2/6 signal transduction. PMID: 23626692
- Cell activation by Ureaplasma parvum and urealyticum seem to require lipid raft function and formation of heterotypic receptor complexes comprising of TLR2 and TLR6 on the cell surface and TLR9 intracellularly. PMID: 23593431
- The study shows that genetic variation within the TLR10/1/6 locus is the major common genetic factor explaining interindividual variation in TLR1/2-mediated cytokine responses. PMID: 23151486
- Women who carried the TLR6 variant were less likely to have upper genital tract infection and inflammation. PMID: 23255565
- Women with microbial invasion of the amniotic cavity and histological chorioamniotis had higher amniotic fluid sTLR1, 2 and 6 levels. PMID: 22280448
- Data indicate that R753Q TLR2 showed impaired tyrosine phosphorylation, dimerization with TLR6 and MyD88 recruitment. PMID: 22992740
- The results showed that the genetic markers in TLR1, TLR4, TLR5 TLR6, and TLR10 were associated with the occurrence of acute Graft-versus-host disease following hematopoietic stem cell transplantation PMID: 22703024
- Single nucleotide polymorphisms in TLR6 gene is associated with the inverse association between childhood acute lymphoblastic leukemia and atopic disease. PMID: 22134717
- No TLR6 polymorphisms were detected in Korean subjects. PMID: 22219617
顯示更多
收起更多
-
亞細胞定位:Cell membrane; Single-pass type I membrane protein. Cytoplasmic vesicle, phagosome membrane; Single-pass type I membrane protein. Membrane raft. Golgi apparatus.
-
蛋白家族:Toll-like receptor family
-
組織特異性:Detected in monocytes, CD11c+ immature dendritic cells, plasmacytoid pre-dendritic cells and dermal microvessel endothelial cells.
-
數據庫鏈接:
Most popular with customers
-
-
YWHAB Recombinant Monoclonal Antibody
Applications: ELISA, WB, IHC, IF, FC
Species Reactivity: Human, Mouse, Rat
-
Phospho-YAP1 (S127) Recombinant Monoclonal Antibody
Applications: ELISA, WB, IHC
Species Reactivity: Human
-
-
-
-
-